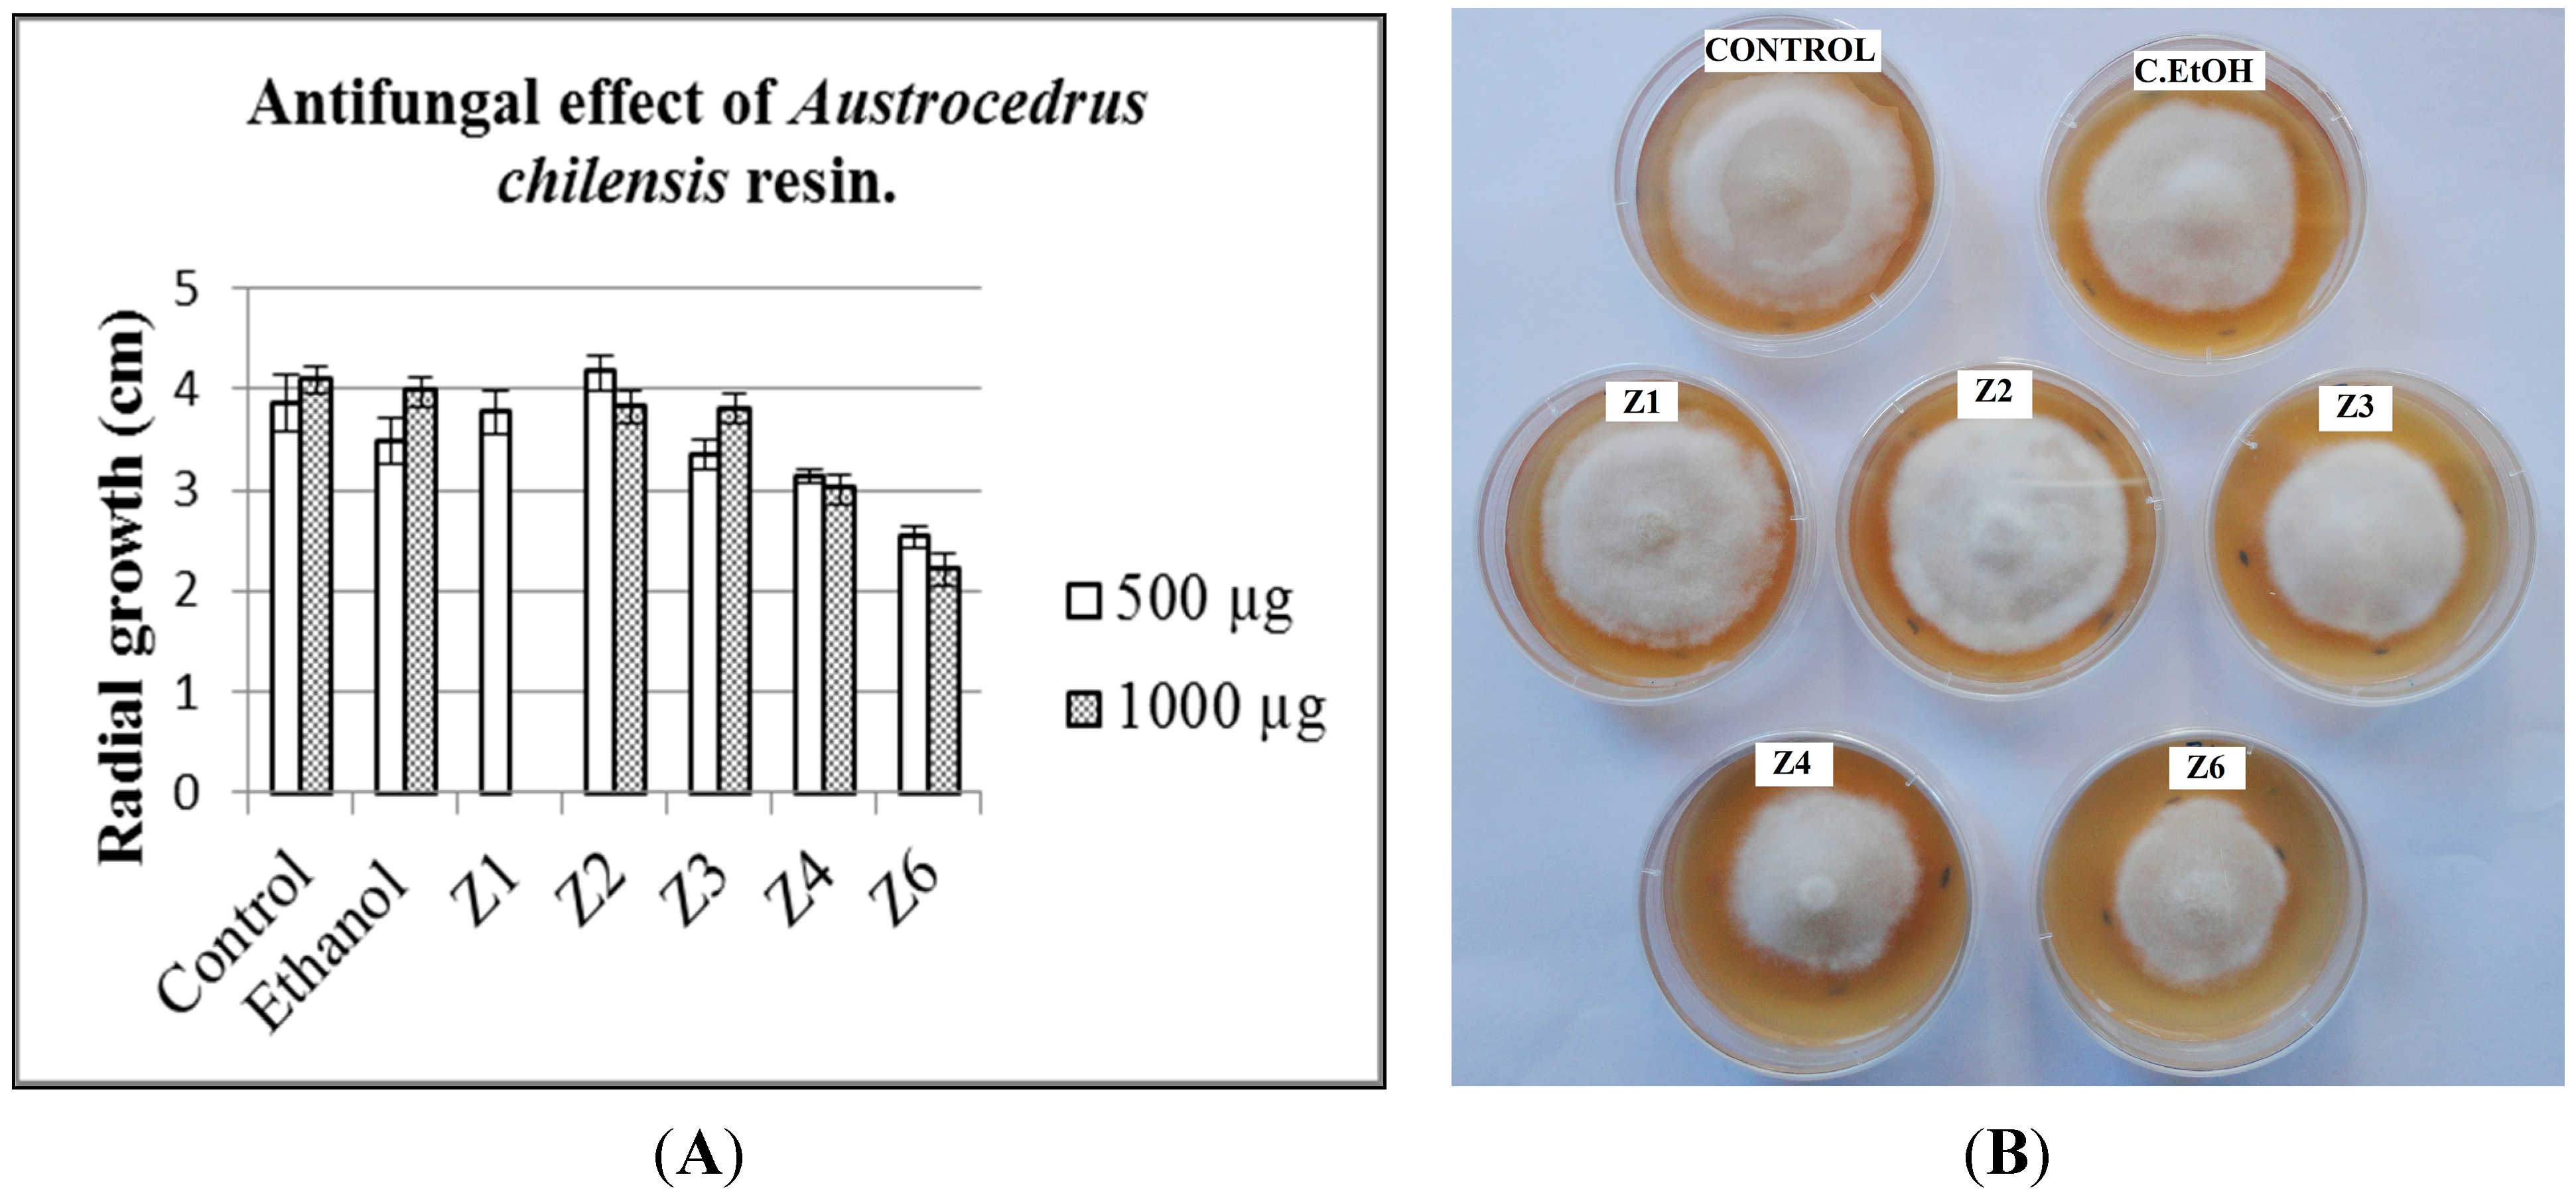

Phytophthora austrocedri Elicitates Changes in Diterpene Profile of Austrocedrus chilensis
Abstract
:1. Introduction
2. Results and Discussion
2.1. Antifungal Activity
| Tree | Gender | Sample Number | Observations |
|---|---|---|---|
| A03 | F | AR-01 | Artificially inoculated |
| A07 | F | AR-02, AR-03, AR-04 | Artificially inoculated |
| A08 | M | AR-05, AR-06 | Healthy and artificially infected zones |
| A09 | F | AR-07, AR-08, AR-09 | Artificially inoculated |
| A06 | F | AR-10 | Artificially inoculated |
| A18 | U | AR-11, AR-12 | Artificially inoculated |
| A21 | U | AR-13 | Artificially inoculated |
| I01 | U | AR-14 | Infected, natural lesion |
| I02 | U | AR-15 | Infected, natural lesion * |
| S01 | F | AR-16 | Healthy tree, naturally exuded resin |
| S02 | F | AR-17 | Healthy tree, naturally exuded resin |
| S03 | F | AR-18 | Healthy tree, naturally exuded resin |
| S04 | F | AR-19 | Healthy tree, naturally exuded resin |
| S05 | M | AR-20 | Healthy tree, naturally exuded resin |
| S06 | M | AR-21 | Healthy tree, naturally exuded resin |
| S07 | M | AR-22 | Healthy tree, naturally exuded resin |
| S08 | M | AR-23 | Healthy tree, naturally exuded resin |
| S09 | M | AR-24 | Healthy tree, naturally exuded resin |

2.2. Resin Profiling by GC-MS and 1H-NMR



3. Experimental Section
3.1. Plant Material
3.2. General Procedures

3.3. Resin Analysis by TLC and Isolation of the Resin Constituents
3.4. Antifungal Activity Assays
3.5. GC-MS Analysis
3.6. 1H-NMR Analysis
4. Conclusions
Acknowledgments
Author Contributions
Conflicts of Interest
References and Notes
- Dell, B.; McComb, A.J. Plant resins-their formation, secretion and possible functions. Adv. Bot. Res. 1979, 6, 277–316. [Google Scholar]
- Phillips, M.A.; Croteau, R.B. Resin-based defences in conifers. Trends Plant Sci. 1999, 4, 184–190. [Google Scholar] [CrossRef]
- Franceschi, V.R.; Krokene, P.; Christiansen, E.; Krekling, T. Anatomical and chemical defenses of conifer bark against bark beetles and other pests. New Phytol. 2005, 167, 353–376. [Google Scholar] [CrossRef] [PubMed]
- Konno, K. Plant latex and other exudates as plant defense systems: Roles of various defence chemicals and proteins contained therein. Phytochemistry 2011, 72, 1510–1530. [Google Scholar] [CrossRef] [PubMed]
- Martin, D.; Tholl, D.; Gershenzon, J.; Bohlmann, J. Methyl jasmonate induces traumatic resin ducts, terpenoid resin biosynthesis, and terpenoid accumulation in developing xylem of Norway spruce stems. Plant Physiol. 2002, 129, 1003–1018. [Google Scholar] [PubMed]
- Miller, B.; Madilao, L.L.; Ralph, S.; Bohlmann, J. Insect-induced conifer defense. White pine weevil and methyl jasmonate induce traumatic resinosis, de novo formed volatile emissions, and accumulation of terpenoid synthase and putative octadecanoid pathway transcripts in Sitka spruce. Plant Physiol. 2005, 137, 369–382. [Google Scholar] [CrossRef] [PubMed]
- Nagy, N.E.; Kroken, P.; Solheim, H. Anatomical-based defense responses of Scots pine (Pinus sylvestris) stems to two fungal pathogens. Tree Physiol. 2006, 26, 159–167. [Google Scholar] [CrossRef] [PubMed]
- Keeling, C.I.; Bohlmann, J. Resin diterpene acids in conifers. Phytochemistry 2006, 67, 2415–2423. [Google Scholar] [CrossRef] [PubMed]
- Yang, N.Y.; Liu, L.; Tao, W.W.; Duan, J.A.; Tian, L.J. Diterpenoids from Pinus massoniana resin and their cytotoxicity against A431 and A549 cells. Phytochemistry 2010, 71, 1528–1533. [Google Scholar] [CrossRef] [PubMed]
- Cox, R.E.; Yamamoto, S.; Otto, A.; Simoneit, B.R.T. Oxygenated di- and tricyclic diterpenoids of shouthern hemisphere conifers. Biochem. Syst. Ecol. 2007, 35, 342–362. [Google Scholar] [CrossRef]
- Jossang, J.; Bel-Kassaoui, H.; Jossang, A.; Seuleiman, M.; Nel, A. Quesnoin, a novel pentacyclic ent-diterpene from 55 million years old Oise amber. J. Org. Chem. 2008, 73, 412–417. [Google Scholar] [CrossRef] [PubMed]
- Lambert, J.B.; Wu, Y.; Santiago-Blay, J.A. Taxonomic and chemical relationships revealed by nuclear magnetic resonance spectra of plant exudates. J. Nat. Prod. 2005, 68, 635–648. [Google Scholar] [CrossRef] [PubMed]
- Lambert, J.B.; Kozminski, M.A.; Santiago-Blay, J.A. Distinctions among conifer exudates by proton magnetic resonance spectroscopy. J. Nat. Prod. 2007, 70, 1283–1294. [Google Scholar] [CrossRef] [PubMed]
- Otto, A.; Simoneit, B.R.T.; Rember, W.C. Resin compounds from the seed cones of three fossil conifer species from the Miocene Clarkia flora, Emerald Creek, Idaho, USA, and from related extant species. Rev. Palaeobot. Palynol. 2003, 126, 225–241. [Google Scholar] [CrossRef]
- Yamamoto, S.; Otto, A.; Simoneit, B.R.T. Lignans in resin of Araucaria angustifolia by gas chromatography/mass spectrometry. J. Mass Spectrom. 2004, 39, 1337–1347. [Google Scholar] [CrossRef] [PubMed]
- Cool, L.G.; Power, A.B.; Zavarin, E. Variability of foliage terpenes of Fitzroya cupressoides. Biochem. Syst. Ecol. 1991, 19, 421–432. [Google Scholar] [CrossRef]
- Cool, L.G. Sesquiterpene alcohols from foliage of Fitzroya cupressoides. Phytochemistry 1996, 42, 1015–1019. [Google Scholar] [CrossRef]
- Olate, V.R.; Goikoetxeaundia Uzandizaga, O.; Schmeda-Hirschmann, G. Resin diterpenes from Austrocedrus chilensis. Molecules 2011, 16, 10653–10667. [Google Scholar] [CrossRef] [PubMed]
- Olate, V.R.; Soto, A. Schmeda-Hirschmann, G. Seasonal variation and resin composition in the Andean tree Austrocedrus chilensis. Molecules 2014, 19, 6489–6503. [Google Scholar] [CrossRef] [PubMed]
- Greslebin, A.G.; Hansen, E.M.; Sutton, W. Phytophthora austrocedrae sp. nov., a new species associated with Austrocedrus chilensis mortality in Patagonia (Argentina). Mycol. Res. 2007, 111, 308–316. [Google Scholar] [CrossRef] [PubMed]
- La Manna, L.; Matteucci, S.D.; Kitzberger, T. Abiotic factors related to the incidence of the Austrocedrus chilensis disease syndrome at a landscape scale. For. Ecol. Manag. 2008, 256, 1087–1095. [Google Scholar] [CrossRef]
- Greslebin, A.G.; Hansen, E.M. Pathogenicity of Phytophthora austrocedrae on Austrocedrus chilensis and its relation with mal del ciprés in Patagonia. Plant Pathol. 2010, 59, 604–612. [Google Scholar] [CrossRef]
- Bunny, F.; Tippett, J. Inhibitory effects of Pinus radiate and P. pinaster resin on growth of four Phytophthora species. Australas. Plant Pathol. 1988, 17, 14–16. [Google Scholar] [CrossRef]
- Sravani, P.; Kiranmayee, Y.; Narasimha, S.; Reddy, V.S.; Asha, S.; Kumar, R.B. In vitro experimental studies on selected natural gums and resins for their antimicrobial activity. Res. J. Pharm. Biol. Chem. Sci. 2014, 5, 154–172. [Google Scholar]
- Brasier, C.; Webber, J. Sudden larch death. Nature 2010, 466, 824–825. [Google Scholar] [CrossRef] [PubMed]
- Davison, E.M.; Stukely, M.J.C.; Crane, C.E.; Tay, F.C.S. Invasion of phloem and xylem of woody stems and roots of Eucalyptus marginata and Pinus radiata by Phytophthora cinnamomi. Phytopathology 1994, 84, 335–340. [Google Scholar] [CrossRef]
- Durán, A.; Gryzenhout, M.; Slippers, B.; Ahumada, R.; Rotella, A.; Flores, F.; Wingfield, B.D.; Wingfield, M.J. Phytophthora pinifolia sp. nov. associated with a serious needle disease of Pinus radiata in Chile. Plant Path 2008, 57, 715–727. [Google Scholar] [CrossRef]
- Green, S.; Brasier, C.M.; Schlenzig, A.; McCracken, A.; MacAskill, G.A.; Wilson, M.; Webber, J.F. The destructive invasive pathogen Phytophthora lateralis found on Chamaecyparis lawsoniana across the UK. For. Pathol. 2012, 43, 19–28. [Google Scholar]
- Than, D.J.; Hughes, K.J.D.; Boonhan, N.; Tomlinson, J.A.; Woodhall, J.W.; Bellgard, S.E. A TaqMan real-time PCR assay for the detection of Phytophthora “taxon Agathis” in soil, pathogen of Kauri in New Zealand. For. Pathol. 2013, 43, 324–330. [Google Scholar] [CrossRef]
- Krokene, P.; Nagy, N.E.; Krekling, T. Chapter 7. Traumatic resin ducts and polyphenolic parenchyma cells in conifers. In Induced Plant Resistance to Herbivory; Schaller, A., Ed.; Springer Science + Business Media B.V.: Stuttgart, Germany, 2008; p. 480. [Google Scholar]
- Kusumoto, N.; Ashitani, T.; Murayama, T.; Ogiyama, K.; Takahashi, K. Antifungal abietane-type diterpenes from the cones of Taxodium distichum Rich. J. Chem. Ecol. 2010, 36, 1381–1386. [Google Scholar] [CrossRef] [PubMed]
- Matsushita, Y.; Hwang, Y.H.; Sugamoto, K.; Matsui, T. Antimicrobial activity of heartwood components of sugi (Cryptomeria japonica) against several fungi and bacteria. J. Wood Sci. 2006, 52, 552–556. [Google Scholar] [CrossRef]
- Dictionary of Natural Products on DVD, 2015. Chapman and Hall.
- Olivier, D.K.; Van Wyk, B.E. The major diterpenoids of the genus Arctopus (Apiaceae) with notes on their chemotaxonomic and medicinal significance. S. Afr. J. Bot. 2013, 85, 94–98. [Google Scholar] [CrossRef]
- Aranda, G.; El Kortbi, M.S.; Lallemand, J.Y.; Neuman, A.; Hammoumi, A.; Facon, I.; Azerad, R. Microbial transformation of diterpenes: Hydroxylation of sclareol, manool and derivatives by Mucor plumbeus. Tetrahedron 1991, 47, 8339–8350. [Google Scholar] [CrossRef]
- Asakawa, Y.; Noma, Y. 3.21-Biotransformation of di- and triterpenoids, steroids, and miscellaneous synthetic substrates. In Comprehensive Natural Products II; Liu, H.W., Mander, L., Eds.; Elsevier: Oxford, UK, 2010; Volume No. 3, pp. 893–965. [Google Scholar]
- Sample Availability: Samples of the resins are available from the authors.
© 2015 by the authors. Licensee MDPI, Basel, Switzerland. This article is an open access article distributed under the terms and conditions of the Creative Commons Attribution license ( http://creativecommons.org/licenses/by/4.0/).
Share and Cite
Olate, V.R.; Vélez, M.L.; Greslebin, A.; Schmeda-Hirschmann, G. Phytophthora austrocedri Elicitates Changes in Diterpene Profile of Austrocedrus chilensis. Molecules 2015, 20, 15084-15097. https://doi.org/10.3390/molecules200815084
Olate VR, Vélez ML, Greslebin A, Schmeda-Hirschmann G. Phytophthora austrocedri Elicitates Changes in Diterpene Profile of Austrocedrus chilensis. Molecules. 2015; 20(8):15084-15097. https://doi.org/10.3390/molecules200815084
Chicago/Turabian StyleOlate, Verónica Rachel, María Laura Vélez, Alina Greslebin, and Guillermo Schmeda-Hirschmann. 2015. "Phytophthora austrocedri Elicitates Changes in Diterpene Profile of Austrocedrus chilensis" Molecules 20, no. 8: 15084-15097. https://doi.org/10.3390/molecules200815084
APA StyleOlate, V. R., Vélez, M. L., Greslebin, A., & Schmeda-Hirschmann, G. (2015). Phytophthora austrocedri Elicitates Changes in Diterpene Profile of Austrocedrus chilensis. Molecules, 20(8), 15084-15097. https://doi.org/10.3390/molecules200815084







